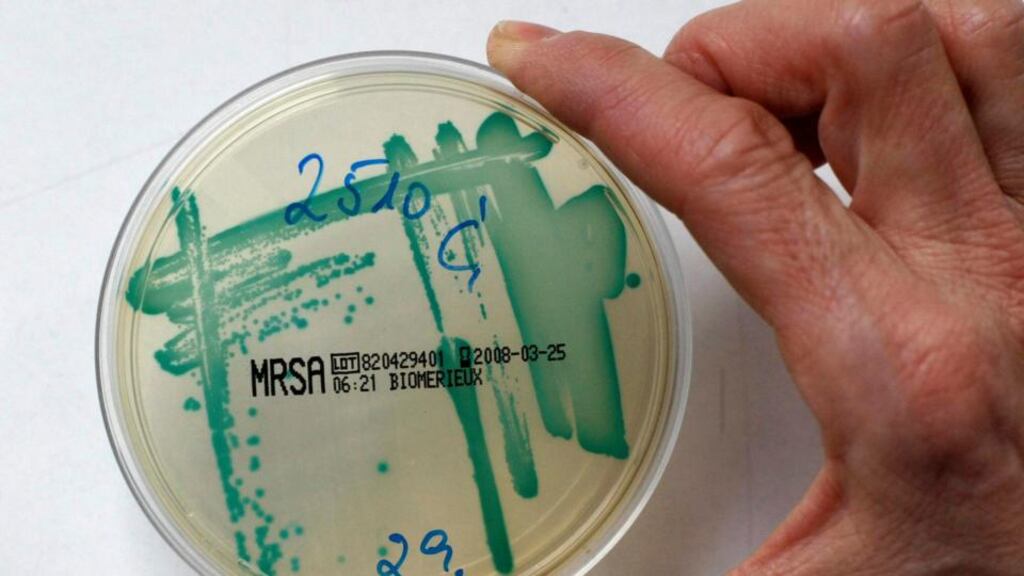
An MRSA bacteria strain in a petri dish. Photograph: Fabrizio Bensch/Files/Reuters

Have you ever watched one of those period films and had a little giggle at how nervous they get at the hint of a cold? The idea of an otherwise healthy person succumbing to infection after a walk in the rain seems like nonsense by modern standards. It's enough to make you feel like we live in a utopia. Yet Alexander Fleming discovered penicillin a mere 86 years ago, and the mass production of this antibiotic was only achieved during the second World War. How quickly we have become complacent.
And complacency is the best description of our relationship with antibiotics. We use antibiotics for even mild infections a healthy immune system could easily tackle; we don’t always follow the instructions to complete the course of drugs; and in some countries antibiotics are used to maximise growth of intensively farmed animals such as chickens.
If you want to understand why this has led to antibiotic-resistant bacteria, you need to think back to a discovery that predates by 70 years Fleming's fortuitous neglect of the washing-up. Charles Darwin described the principles of natural selection in his 1858 opus, and these are exactly the same principles at play in the rise of antibiotic resistance.
The idea that a trait can be changed or exaggerated by selective breeding is familiar to plant and animal breeders. In one of the longest-running experiments in the world, scientists in the University of Illinois have been selectively breeding corn since 1896. Each year they select the corn with the highest oil content as the “parents” of a cross. Over the years the oil content of the corn has risen and risen.
In much the same way, cows were bred for higher milk yields or for larger muscles, and roses were bred for floral display and perfume. But nothing illustrates the power of selection quite like the vision of all the different breeds of dogs that have been created starting from domesticated wolves.
Breeding strong bacteria
By misusing antibiotics, we are performing a huge collective experiment in selective breeding of bacteria. Antibiotics work by interfering with the growth of bacteria. For example, penicillin blocks the synthesis of the bacterial cell wall so the bacteria can't multiply. However, much like no two human beings are genetically identical, there is genetic diversity in bacteria. Some of this diversity makes a few bacteria harder to kill with the antibiotic than others.
Now imagine a hypothetical bacterial infection made up of, say, 10,000 bacterial cells. In this group the large majority are susceptible to the antibiotic, but 50 are mildly resistant. You get prescribed a seven-day course of antibiotics. By day four or five the number of bacteria has dropped down to, say, 100. You are feeling better, and you forget to take the rest of your tablets.
However, whereas most of the susceptible bacteria were quickly killed by the antibiotic, the resistant bacteria had a better survival rate and needed those last two days of antibiotic to be properly finished off. So, perhaps out of these 100 remaining bacteria, 30 are resistant. The frequency of bacterial resistance has just jumped from 0.5 per cent to 30 per cent.
This has the same effect as selecting the largest cows for breeding: the strongest, most resistant bacteria have been selected and they are the parents of the next generation. Eventually bacterial resistance can rise to almost 100 per cent.
Antibiotics are one of the most powerful discoveries of modern medicine, yet we are destroying them by failing to anticipate the power of evolution by natural selection. Kanamycin is an antibiotic that was used in the 1950s. It has become useless because of the rise of kanamycin-resistant bacteria.
MRSA (methicillin-resistant Staphylococcus aureus) has become increasingly common as we continue to be too casual with antibiotics. Until recently MRSA was mostly confined to hospitals, but now it has been found more widely in the community.
The same process that can take a wolf and make a Great Dane or a Chihuahua, can wipe out the usefulness of a whole swathe of medicines.
The geneticist Theodosius Dobzhansky once wrote that “nothing in biology makes sense, except in the light of evolution”. We would do well to remember the power of natural selection and not spoil our own modern medical paradise.
Aoife McLysaght is professor in genetics in Trinity College Dublin, where she leads a research group 
identifying and interpreting the evolutionary patterns in animal genomes